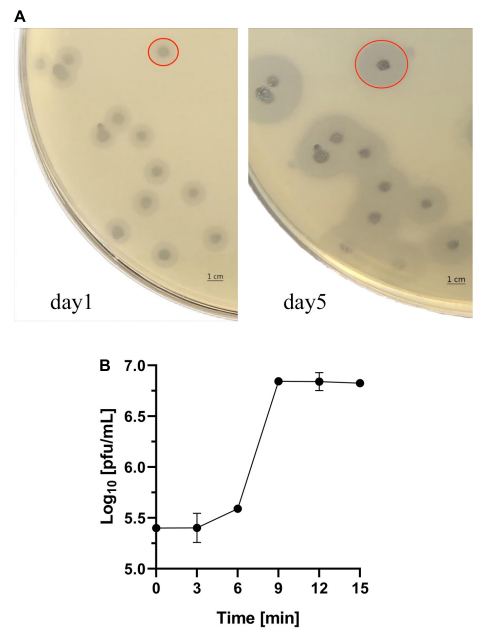
3.png

2022-08-01

《frontiers in Microbiology》
影响因子:6.064
近日,派森诺生物与浙江工业大学合作,在基因组学领域的《frontiers in Microbiology》发表新研究成果!本研究从肺炎克雷伯菌(K. pneumoniae)噬菌体中鉴定到了一种新型的噬菌体编码多糖降解酶K19-Dpo41,且该酶对K19型K. pneumoniae具有特异性的抑制活性。本研究结果为K19-Dpo41不仅在K19型K. pneumoniae荚膜分型中有效提供了有力的初步证据,而且有望在未来开发新的替代治疗K19型CRKP感染的治疗策略。
研究背景
肺炎克雷伯菌(K. pneumoniae)是一种条件致病菌,可引起多种感染,包括尿路感染、菌血症、肺炎和肝脓肿。自1996年发现第一株含有碳青霉烯酶的肺炎克雷伯菌以来,耐碳青霉烯肺炎克雷伯菌(CRKP)很快流行起来,这凸显了包装可用抗生素的问题和对替代治疗的需求。近年来,CRKP和K. pneumoniae菌株在全球的传播显著放大了该病原体的危害,为有效的病原体控制带来了新的挑战。所有这些因素都表明,K. pneumoniae是公共卫生的一个主要问题。
荚膜多糖(CPS),又称K抗原,是包围K. pneumoniae细胞的最外层荚膜层,是K. pneumoniae的重要毒力因子和防御屏障,它使细菌通过克服免疫系统的保护机制在宿主体内生存。该胶囊阻碍抗菌肽的杀菌作用,并阻断补体成分,防止补体介导的杀伤。它进一步损害免疫细胞对K. pneumoniae的吞噬和调理吞噬作用。而噬菌体编码荚膜解聚酶是噬菌体降解宿主细菌CPS的一种酶。最近,对荚膜解聚酶的研究表明,每一种解聚酶都对特定的CPS层具有高度特异性,表明它们可以作为一种简单而经济的方法来区分荚膜类型,并作为相应荚膜类型的肺炎克雷伯菌菌株的抗菌剂。囊状解聚酶的这些特性在抑制CRKP方面具有很大的潜力,因此受到了广泛的关注。截至目前,已发现并报道了23种K型肺炎荚膜解聚酶。其中K19型K. pneumoniae血清型是中国上海当地医院CRKP样本人群中第二大流行血清型,也是日本、马来西亚、新加坡、泰国和越南当地中国成人和海外华人人群中第三大流行血清型。然而,目前还没有关于特异性靶向K19型K. pneumoniae的解聚酶的报道。在本研究中,首次鉴定出一种新的噬菌体来源的解聚酶,该酶特异性靶向k19型K. pneumoniae。结果表明,该解聚酶在推进K19型CRKP感染的荚膜分型和治疗方面具有很大的潜力。
研究材料与方法
>>> 1.实验材料:
上海交通大学医学院瑞金医院原污水中分离得到的SH-KP156570噬菌体
>>> 2.测序平台:
Illumina Hiseq
>>> 3.分析内容:
噬菌体基因组测序,噬菌体一步生长曲线、宿主谱分析,重组解聚酶的克隆、表达、纯化,解聚酶活性测序,抗血清检测,大蜡螟幼虫感染模型等。
研究结果
K. pneumoniae耐药性及荚膜基因型研究
29株临床分离株均为CRKP,对多种抗生素耐药,如头孢呋辛(CXM, 28/29)、阿米卡星(AMK, 15/29)、哌拉西林-他唑巴坦(TZP, 28/29)、左氧氟沙星(LVX, 27/29)、环丙沙星(CIP, 27/29)、头孢他啶(CAZ, 29/29)、头孢哌酮舒巴坦钠(CSL, 27/29)、头孢吡肟(FEP, 29/29)、亚胺培南(IPM, 19/29)、美罗培南耐药(MEM, 28/29)、甲氧苄啶-磺胺甲恶唑(SXT, 17/29)和唑曲南(ATM, 27/29)。
表1:噬菌体SH-KP156570和解聚酶K19-Dpo41的宿主谱分析

SH-KP156570噬菌体对k19型K. Pneumoniae特异
将噬菌体扩散到K. Pneumoniae 6570株上,形成双层琼脂平板,观察到清除的斑块形成和微弱的晕圈。微弱光晕的大小随着时间的推移而增加,根据之前的研究,猜测可能存在噬菌体衍生的解聚酶。为了了解SH-KP156570与荚膜类型的关系,采用斑点试验对所有29株SH-KP156570进行宿主谱分析。随着时间的推移,所有20株K19型菌株均出现微弱晕圈和鼠疫,而9株非K19型菌株则没有斑块或晕圈。结果表明,SH-KP156570噬菌体只针对K19 CPS具有特异性。
图1:SH-KP156570噬菌体的鉴定
SH-KP156570生命周期的测定
SH-KP156570的生长周期为一步生长曲线。噬菌体潜伏期为6分钟,随后噬菌体子体上升,直到9分钟达到静止噬菌体。爆发大小约为每个感染细胞80 PFU。
SH-KP156570噬菌体基因组DNA测序及注释
SH-KP156570噬菌体的基因组大小为38667 bp, GC含量为50.85%。基因预测得到47个ORF,其中有29个(61.7%)编码假定的功能蛋白。这些ORFs的平均大小为851 bp。噬菌体编码蛋白根据其功能可分为:DNA包装和形态相关蛋白(6种)、DNA复制/重组/修饰蛋白(16种)、宿主溶解蛋白(4种)和未知蛋白(3种),其余基因编码为假定蛋白。在SH-KP156570基因组中未发现整合酶基因、毒力因子、毒素或耐药性基因。编码尾纤维蛋白的ORF41基因(2292bp)被预测为解聚酶编码基因(CPS)。ORF41蛋白n端保守结构域(11 ~ 113 aa)与T7噬菌体n端序列高度相似,而中部区域(252 ~ 296 aa)与果胶裂解酶高度相似。该ORF蛋白含有一个β-螺旋果胶裂解酶结构域,与来自大肠杆菌噬菌体CBA120的尾刺蛋白TSP3。上述结果提示ORF41蛋白可能是SHKP156570噬菌体中的一种多糖解聚酶。

图2:噬菌体SH-KP156570基因组的生物信息学分析
重组解聚酶K19-Dpo41的解聚活性
将SH-KP156570噬菌体ORF41基因克隆到pSUMO3表达载体中,重组K19ORF41-pSUMO3蛋白经Ni-NTA柱纯化表达。经SDS-PAGE凝胶分析,纯化后的K19-Dpo41(约84 kDa)纯度达95%以上。将纯化的重组解聚酶K19-Dpo41稀释至不同浓度(4.2µg/mL ~ 0.42 mg/mL)进行斑点试验,评价多糖解聚活性。K19-Dpo41浓度低至4.2µg/mL时,可观察到清晰的光晕。SEC-HPLC结果证实K19-Dpo41对肺炎克雷伯菌6570株CPS有解聚作用。未处理的CPS显示单峰,停留时间为12 - 16分钟。然而,在37◦C下与K19-Dpo41孵养30分钟后,CPS的峰值消失,表明CPS被K19-Dpo41降解。

图3:重组解聚酶K19-Dpo41的表达及解聚活性
用斑点法检测K19-Dpo41对29株K. Pneumoniae活性发现,在K19型K. Pneumoniae培养板上,重组蛋白K19-Dpo41产生半透明的晕圈。非K19型K. Pneumoniae未见透明斑形成。结果表明,解聚酶K19-Dpo41与亲本噬菌体SHKP156570一样,对K19型K. Pneumoniae具有特异性。
K19-Dpo41增加K. Pneumoniae 6570株对血清杀伤的敏感性
孵育1 h后,K19- dpo41处理后的菌群存活率较未处理菌群及K64-ORF41处理后的菌群存活率降低约70%,表明K19- dpo41可提高K19型K. Pneumoniae对血清杀伤的敏感性。

图4:K19-Dpo41对抗肺炎克雷伯菌感染的影响
K19-Dpo41对大蜡螟肺炎克雷伯菌感染模型的影响
采用anti-K. Pneumoniae感染大蜡螟幼虫模型,评价K19-Dpo41对K. Pneumoniae的感染效果。结果表明,在K. Pneumoniae感染组,90%的幼虫注射肺炎克雷伯菌6570株后3 d内死亡。而K19-Dpo41单次给药30 min可使幼虫存活率提高到50%,同样给药5 min可达到70%。注射PBS组未见幼虫死亡。
结论
研究表明来自SH-KP156570噬菌体的新型解聚酶K19-Dpo41能够降解K19型K. Pneumoniae的荚膜,促进细菌对血清补体裂解的敏感性,并有效提高大蜡螟幼虫在体内感染模型中的存活率。本研究鉴定的这种解聚酶及其酶活性肯定会被发现在治疗、预防和控制严重CRKP感染以及更准确、高效的荚膜分型方面有益的应用。
本研究的denovo测序由上海派森诺生物科技有限公司完成。如需进一步讨论,欢迎发邮件或者致电我们哟(邮箱地址:microsupport@personalbio.cn,联系电话:025-56165883-832)!
文章索引:Hua Y, Wu Y, Guo M, et al. Characterization and Functional Studies of a Novel Depolymerase Against K19-Type Klebsiella pneumoniae[J]. Frontiers in Microbiology, 2022, 13.